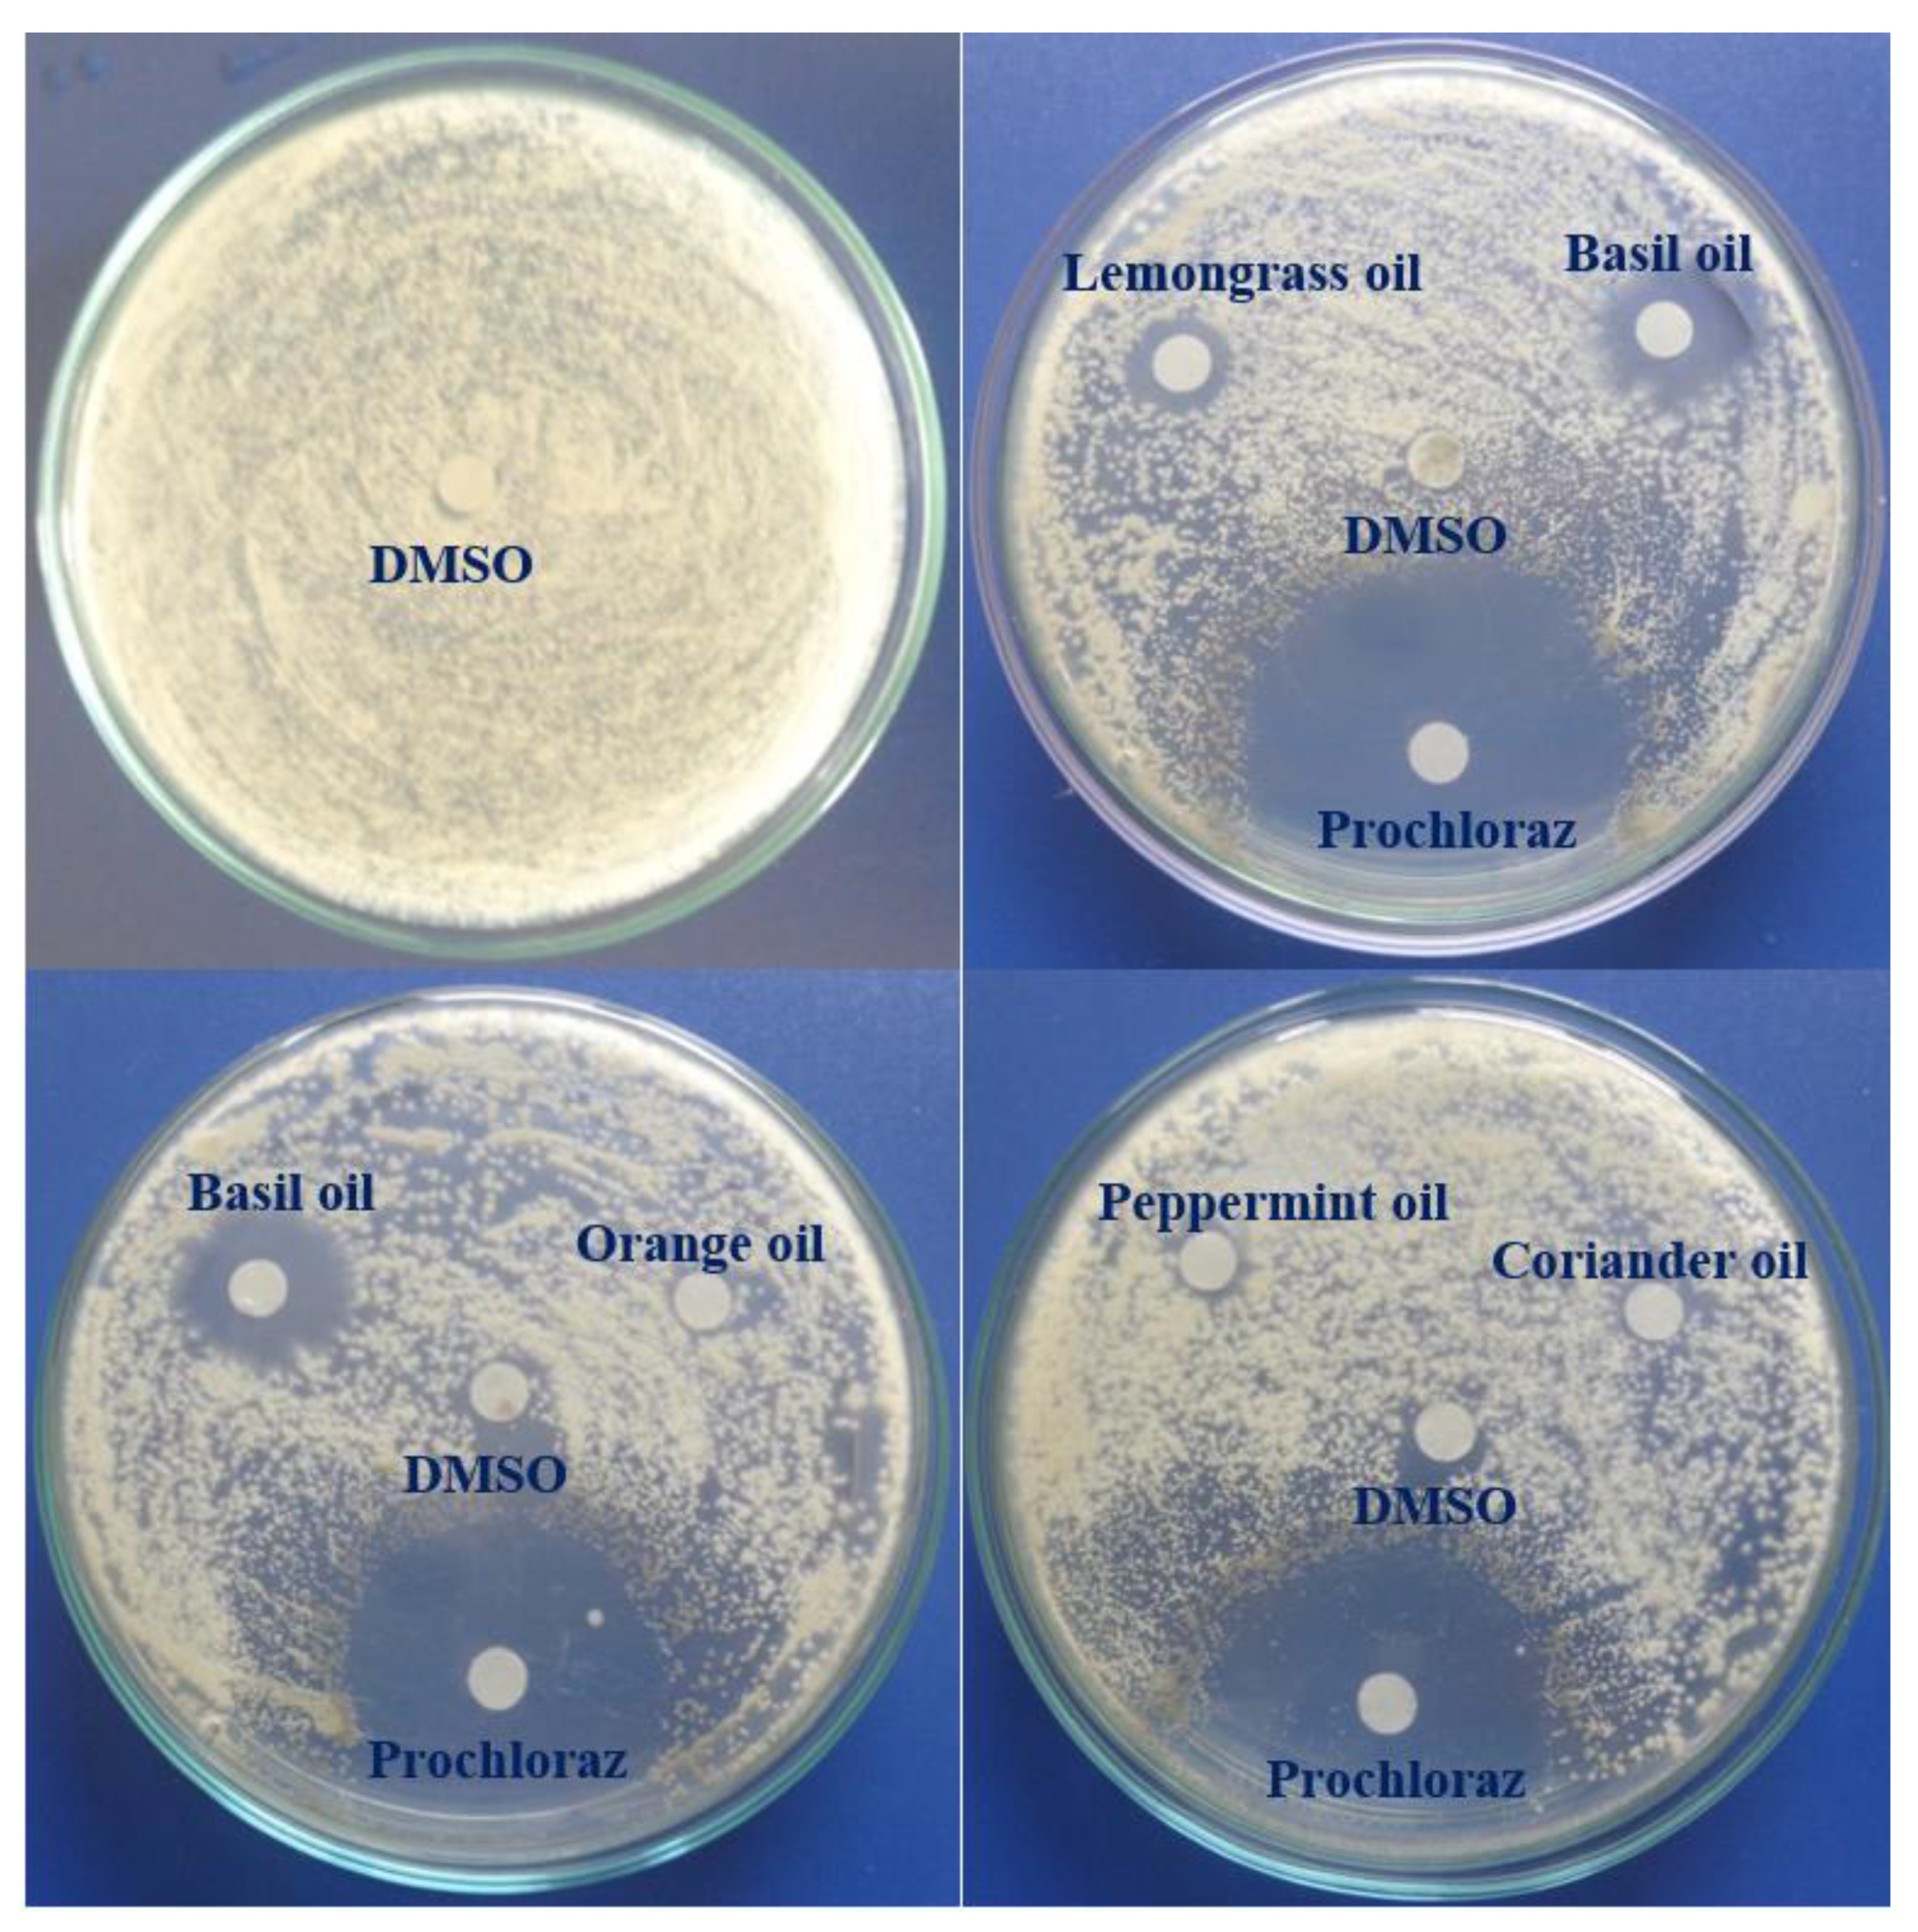

Use of Essential Oils for the Control of Anthracnose Disease Caused by Colletotrichum acutatum on Post-Harvest Mangoes of Cat Hoa Loc Variety
Abstract
1. Introduction
2. Materials and Methods
2.1. Sample Collection
2.2. Isolation of Anthracnose-Causing Fungi and Pathogenicity Test
2.3. Selection of the Most Pathogenic Fungus
2.4. Identification of the Most Pathogenic Fungus
2.5. Essential Oil Extraction and Collection
2.6. Gas Chromatography–Mass Spectrometry Analysis
2.7. In Vitro Antifungal Activity of EOs
2.8. Determination of Minimum Inhibitory Concentration (MIC) of EOs
2.9. Evaluation of the Effect of EOs on Mango Fruit Peels
2.10. Effect of EOs on Inhibiting Anthracnose Development on Mango Fruits
2.11. Statistical Analysis
3. Results and Discussion
3.1. Chemical Components of EOs
3.2. Isolation of the Most Pathogenic Fungus
3.3. Identification of the Most Pathogenic Fungus
3.4. In Vitro Antifungal Activity of EOs against C. acutatum
3.5. Effect of EOs on Fruit Peel of Cat Hoa Loc Mangoes
3.6. Effect of Basil Oil on Anthracnose Development on Mango Fruits
4. Conclusions
Author Contributions
Funding
Institutional Review Board Statement
Informed Consent Statement
Conflicts of Interest
References
- Do Chi, T.; Kunasakdakul, K. Inhibition of Colletotrichum gloeosporioides and control of postharvest anthracnose disease on mango fruit using propionic acid combined with bee-carnauba wax emulsion. J. Agric. Sci. 2013, 5, 110–116. [Google Scholar]
- Combrinck, S.; Regnier, T.; Kamatou, G.P.P. In vitro activity of eighteen essential oils and some major components against common postharvest fungal pathogens of fruit. Ind. Crop. Prod. 2011, 33, 344–349. [Google Scholar] [CrossRef]
- Tisserand, R.; Young, R. Essential Oil Safety-e-Book: A Guide for Health Care Professionals; Elsevier: Amsterdam, The Netherlands, 2013. [Google Scholar]
- Perumal, A.B.; Sellamuthu, P.S.; Nambiar, R.B.; Sadiku, E.R. Antifungal activity of five different essential oils in vapour phase for the control of Colletotrichum gloeosporioides and Lasiodiplodia theobromae in vitro and on mango. Int. J. Food Sci. Technol. 2016, 51, 411–418. [Google Scholar] [CrossRef]
- Rabari, V.P.; Chudashama, K.S.; Thaker, V.S. In vitro Screening of 75 Essential Oils against Colletotrichum gloeosporioides: A Causal Agent of Anthracnose Disease of Mango. Int. J. Fruit Sci. 2018, 18, 1–13. [Google Scholar] [CrossRef]
- Sefu, G.; Satheesh, N.; Berecha, G. Effect of essential oils treatment on anthracnose (Colletotrichum gloeosporioides) disease development, quality and shelf life of mango fruits (Mangifera indica L). Am. Eurasian J. Agric. Environ. Sci. 2015, 15, 2160–2169. [Google Scholar]
- Duamkhnmanee, R. Natural essential oils from lemon grass (Cymbopogon citratus) to control postharvest anthracnose of mango fruit. Int. J. Biotechnol. 2008, 10, 104. [Google Scholar] [CrossRef]
- Karunanayake, K.O.L.C.; Liyanage, K.C.M.; Jayakody, L.K.R.R.; Somaratne, S. Basil oil incorporated beeswax coating to increase shelf life and reduce anthracnose development in mango cv. Willard. Ceylon J. Sci. 2020, 49, 355. [Google Scholar] [CrossRef]
- de Oliveira, K.Á.R.; Berger, L.R.R.; de Araújo, S.A.; Câmara, M.P.S.; de Souza, E.L. Synergistic mixtures of chitosan and Mentha piperita L. essential oil to inhibit Colletotrichum species and anthracnose development in mango cultivar Tommy Atkins. Food Microbiol. 2017, 66, 96–103. [Google Scholar] [CrossRef]
- Abd-alla, M.A.; Haggag, W.M. Use of some essential oils as postharvest botanical fungicides in the management of anthracnose disease of mango fruits caused by Colletotrichum gloeosporioides. Int. J. Agric. For. 2013, 3, 1–6. [Google Scholar]
- Perumal, A.B.; Sellamuthu, P.S.; Nambiar, R.B.; Sadiku, E.R. Effects of Essential Oil Vapour Treatment on the Postharvest Disease Control and Different Defence Responses in Two Mango (Mangifera indica L.) Cultivars. Food Bioprocess Technol. 2017, 10, 1131–1141. [Google Scholar] [CrossRef]
- Agrios, G.N. Plant Pathology, 5th ed.; Academic Press: New York, NY, USA, 2005. [Google Scholar]
- Sutton, B.C. The Coelomycetes: Fungi Imperfecti with Pycnidia Acervuli and Stomata; Commonwealth Mycological Institute: Kew, UK, 1980; 696p. [Google Scholar]
- Danh, L.T.; Truong, P.; Mammucari, R.; Foster, N. Effect of Calcium on Growth Performance and Essential Oil of Vetiver Grass (Chrysopogon zizanioides) Grown on Lead Contaminated Soils. Int. J. Phytoremed. 2011, 13, 154–165. [Google Scholar] [CrossRef]
- Tuan, N.T.; Dang, L.N.; Huong, B.T.C.; Danh, L.T. One step extraction of essential oils and pectin from pomelo (Citrus grandis) peels. Chem. Eng. Process. Process Intensif. 2019, 142, 107550. [Google Scholar] [CrossRef]
- Adams, R.P. Identification of Essential Oil Components by Gas Chromatography/Mass Spectrometry, 4th ed.; Allured Publishing Corporation: Carol Stream, IL, USA, 2007. [Google Scholar]
- Stević, T.; Berić, T.; Šavikin, K.; Sokovic, M.; Gođevac, D.; Dimkić, I.; Stanković, S. Antifungal activity of selected essential oils against fungi isolated from medicinal plant. Ind. Crop. Prod. 2014, 55, 116–122. [Google Scholar] [CrossRef]
- Le Nguyen Doan Duy, N.T.; Tuyen, K.; Lan, L.T.; Ha, N.C. Study on the use of chitosan to inhibit Colletotrichum gloeosporioides isolated from Cat Hoa Loc mango infected by anthracnose. Can Tho Univ. J. Sci. 2014, 154–161. (In Vietnamese) [Google Scholar]
- Oxenham, S.K.; Svoboda, K.P.; Walters, D.R. Antifungal Activity of the Essential Oil of Basil (Ocimum basilicum). J. Phytopathol. 2005, 153, 174–180. [Google Scholar] [CrossRef]
- Grayer, R.J.; Kite, G.; Goldstone, F.J.; Bryan, S.E.; Paton, A.; Putievsky, E. Infraspecific taxonomy and essential oil chemotypes in sweet basil, Ocimum basilicum. Phytochemistry 1996, 43, 1033–1039. [Google Scholar] [CrossRef]
- Marotti, M.; Piccaglia, R.; Giovanelli, E. Differences in Essential Oil Composition of Basil (Ocimum basilicum L.) Italian Cultivars Related to Morphological Characteristics. J. Agric. Food Chem. 1996, 44, 3926–3929. [Google Scholar] [CrossRef]
- Sishu, R.; Tadesse, S.; Bucar, F.; Asres, K. Composition and the antioxidant activity of the essential oils of Ocimum basilicum var. thyrsiflorum and Ocimum americanum. Int. J. Essent Oil Ther. 2010, 4, 64–68. [Google Scholar]
- Wijesekera, R.; Chichester, C.O. The chemistry and technology of cinnamon. Crit. Rev. Food Sci. Nutr. 1978, 10, 1–30. [Google Scholar] [CrossRef]
- Tao, D.; Li, Y.; Lu, D.; Luo, Y.; Yu, S.; Ye, S. The essential oil components of Cinnamomum cassia: An analysis under different thinning models of plantation Pinus massoniana. J. For. Res. 2016, 27, 707–717. [Google Scholar] [CrossRef]
- Liu, X.; Cheng, J.; Zhao, N.; Liu, Z. Insecticidal activity of essential oil of Cinnamomum cassia and its main constituent, trans-Cinnamaldehyde, against the booklice, Liposcelis bostrychophila. Trop. J. Pharm. Res. 2014, 13, 1697. [Google Scholar] [CrossRef][Green Version]
- Ma, Y.N.; Chen, C.J.; Li, Q.; Wang, W.; Xu, F.R.; Cheng, Y.X.; Dong, X. Fungicidal activity of essential oils from Cinnamomum cassia against the Pathogenic Fungi of Panax notoginseng Diseases. Chem. Biodivers. 2019, 16, e1900416. [Google Scholar] [CrossRef] [PubMed]
- Kasim, N.N.; Ismail, S.N.A.S.; Masdar, N.D.; Hamid, F.A.; Nawawi, W.I. Extraction and potential of cinnamon essential oil towards repellency and insecticidal activity. Int. J. Sci. Res. Publ. 2014, 4, 2250–3153. [Google Scholar]
- Jeyaratnam, N.; Nour, A.H.; Kanthasamy, R.; Nour, A.H.; Yuvaraj, A.; Akindoyo, J.O. Essential oil from Cinnamomum cassia bark through hydrodistillation and advanced microwave assisted hydrodistillation. Ind. Crop. Prod. 2016, 92, 57–66. [Google Scholar] [CrossRef]
- Kačániová, M.; Galovičová, L.; Valková, V.; Tvrdá, E.; Terentjeva, M.; Žiarovská, J.; Kunová, S.; Savitskaya, T.; Grinshpan, D.; Štefániková, J.; et al. Antimicrobial and antioxidant activities of Cinnamomum cassia essential oil and its application in food preservation. Open Chem. 2021, 19, 214–227. [Google Scholar] [CrossRef]
- Chang, C.-T.; Chang, W.-L.; Hsu, J.-C.; Shih, Y.; Chou, S.-T. Chemical composition and tyrosinase inhibitory activity of Cinnamomum cassia essential oil. Bot. Stud. 2013, 54, 10. [Google Scholar] [CrossRef]
- Li, Y.; Tan, B.; Cen, Z.; Fu, Y.; Zhu, X.; He, H.; Kong, D.; Wu, H. The variation in essential oils composition, phenolic acids and flavonoids is correlated with changes in antioxidant activity during Cinnamomum loureirii bark growth. Arab. J. Chem. 2021, 14, 103249. [Google Scholar] [CrossRef]
- Aungtikun, J.; Soonwera, M. Improved adulticidal activity against Aedes aegypti (L.) and Aedes albopictus (Skuse) from synergy between Cinnamomum spp. essential oils. Sci. Rep. 2021, 11, 4685. [Google Scholar] [CrossRef]
- Seshadri, V.D.; Balasubramanian, B.; Al-Dhabi, N.A.; Esmail, G.A.; Arasu, M.V. Essential oils of Cinnamomum loureirii and Evolvulus alsinoides protect guava fruits from spoilage bacteria, fungi and insect (Pseudococcus longispinus). Ind. Crop. Prod. 2020, 154, 112629. [Google Scholar] [CrossRef]
- Li, Y.-Q.; Kong, D.-X.; Wu, H. Analysis and evaluation of essential oil components of cinnamon barks using GC–MS and FTIR spectroscopy. Ind. Crop. Prod. 2013, 41, 269–278. [Google Scholar] [CrossRef]
- Li, R.; Wang, Y.; Jiang, Z.-T.; Jiang, S. Chemical Composition of the Essential Oils of Cinnamomum loureirii Nees. From China Obtained by Hydrodistillation and Microwave-assisted Hydrodistillation. J. Essent. Oil Res. 2010, 22, 129–131. [Google Scholar] [CrossRef]
- Chinh, H.V.; Luong, N.X.; Thin, D.B.; Dai, D.N.; Hoi, T.M.; Ogunwande, I.A. Essential Oils Leaf of Cinnamomum glaucescens and Cinnamomum verum from Vietnam. Am. J. Plant Sci. 2017, 8, 2712–2721. [Google Scholar] [CrossRef][Green Version]
- Abd El-Hack, M.E.; Alagawany, M.; Abdel-Moneim, A.-M.E.; Mohammed, N.G.; Khafaga, A.F.; Bin-Jumah, M.; Othman, S.I.; Allam, A.A.; Elnesr, S.S. Cinnamon (Cinnamomum zeylanicum) oil as a potential alternative to antibiotics in poultry. Antibiotics 2020, 9, 210. [Google Scholar] [CrossRef]
- Paranagama, P.; Wimalasena, S.; Jayatilake, G.S.; Jayawardena, A.L.; Senanayake, U.; Mubarak, A. A comparison of essential oil constituents of bark, leaf, root and fruit of cinnamon (Cinnamomum zeylanicum Blum) grown in Sri Lanka. J. Natl. Sci. Found. Sri Lanka 2001, 29, 147. [Google Scholar] [CrossRef]
- Koketsu, M.; Gonçalves, S.L.; Godoy, R.L.D.O.; Lopes, D.; Morsbach, N. The bark and leaf essential oils of cinnamon (Cinnamomum verum Presl) grown at Parana, Brazil. Food Sci. Technol. 1997, 17, 281–285. [Google Scholar]
- Jantan, I.; Goh, S.H. Essential Oils ofCinnamomumSpecies from Peninsular Malaysia. J. Essent. Oil Res. 1992, 4, 161–171. [Google Scholar] [CrossRef]
- Majewska, E.; Kozłowska, M.; Gruczyńska-Sękowska, E.; Kowalska, D.; Tarnowska, K. Lemongrass (Cymbopogon citratus) Essential Oil: Extraction, Composition, Bioactivity and Uses for Food Preservation—A Review. Pol. J. Food Nutr. Sci. 2019, 69, 327–341. [Google Scholar] [CrossRef]
- Hanaa, A.M.; Sallam, Y.; El-Leithy, A.; Aly, S.E. Lemongrass (Cymbopogon citratus) essential oil as affected by drying methods. Ann. Agric. Sci. 2012, 57, 113–116. [Google Scholar] [CrossRef]
- Mirghani, M.E.S.; Liyana, Y.; Parveen, J. Bioactivity analysis of lemongrass (Cymbopogan citratus) essential oil. Int. Food Res. J. 2012, 19, 569. [Google Scholar]
- Schaneberg, B.T.; Khan, I.A. Comparison of Extraction Methods for Marker Compounds in the Essential Oil of Lemon Grass by GC. J. Agric. Food Chem. 2002, 50, 1345–1349. [Google Scholar] [CrossRef]
- Abdel-Hameed, E.-S.S.; Salman, M.S.; Fadl, M.A.; Elkhateeb, A.; El-Awady, M.A. Chemical Composition of Hydrodistillation and Solvent free Microwave Extraction of Essential Oils from Mentha piperita L. Growing in Taif, Kingdom of Saudi Arabia, and Their Anticancer and Antimicrobial Activity. Orient. J. Chem. 2018, 34, 222–233. [Google Scholar] [CrossRef]
- Satmi, F.R.S.; Hossain, M.A. In vitro antimicrobial potential of crude extracts and chemical compositions of essential oils of leaves of Mentha piperita L native to the Sultanate of Oman. Pac. Sci. Rev. A Nat. Sci. Eng. 2016, 18, 103–106. [Google Scholar] [CrossRef]
- Yu, X.; Liang, C.; Fang, H.; Qi, X.; Li, W.; Shang, Q. Variation of trichome morphology and essential oil composition of seven Mentha species. Biochem. Syst. Ecol. 2018, 79, 30–36. [Google Scholar] [CrossRef]
- Samber, N.; Khan, A.; Varma, A.; Manzoor, N. Synergistic anti-candidal activity and mode of action of Mentha piperita essential oil and its major components. Pharm. Biol. 2015, 53, 1496–1504. [Google Scholar] [CrossRef]
- Singh, P.; Pandey, A.K. Prospective of Essential Oils of the Genus Mentha as Biopesticides: A Review. Front. Plant Sci. 2018, 9, 1295. [Google Scholar] [CrossRef] [PubMed]
- Freire, M.M.; Jham, G.N.; Dhingra, O.D.; Jardim, C.M.; Barcelos, R.C.; Valente, V.M.M. Composition, antifungal activity and main fungitoxic components of the essential oil of Mentha piperita L. J. Food Saf. 2011, 32, 29–36. [Google Scholar] [CrossRef]
- Gil, A.; De La Fuente, E.B.; Lenardis, A.E.; López Pereira, M.; Suárez, S.A.; Bandoni, A.; van Baren, C.; di Leo Lira, P.; Ghersa, C.M. Coriander Essential Oil Composition from Two Genotypes Grown in Different Environmental Conditions. J. Agric. Food Chem. 2002, 50, 2870–2877. [Google Scholar] [CrossRef]
- İzgı, M.N.; Telci, İ.; Elmastaş, M. Variation in essential oil composition of coriander (Coriandrum sativum L.) varieties cultivated in two different ecologies. J. Essent. Oil Res. 2017, 29, 494–498. [Google Scholar] [CrossRef]
- Anwar, F.; Sulman, M.; Hussain, A.I.; Saari, N.; Iqbal, S.; Rashid, U. Physicochemical composition of hydro-distilled essential oil from coriander (Coriandrum sativum L.) seeds cultivated in Pakistan. J. Med. Plants Res. 2011, 5, 3537–3544. [Google Scholar]
- Msaada, K.; Hosni, K.; TAARIT, M.B.; Ouchikh, O.; Marzouk, B. Variations in essential oil composition during maturation of coriander (Coriandrum sativum L.) fruits. J. Food Biochem. 2009, 33, 603–612. [Google Scholar] [CrossRef]
- Le Hoang Le Thuy and Pham Van Kim Classification to species of Colletotrichum isolates, causal agent of anthracnose disease on mango and durian in the Mekong delta and test for effectiveness of six fungicides to the fungal species. Can Tho Univ. J. Sci. 2008, 10, 31–40.
- Khan, M.; Chonhenchob, V.; Huang, C.; Suwanamornlert, P. Antifungal Activity of Propyl Disulfide from Neem (Azadirachta indica) in Vapor and Agar Diffusion Assays against Anthracnose Pathogens (Colletotrichum gloeosporioides and Colletotrichum acutatum) in Mango Fruit. Microorganisms 2021, 9, 839. [Google Scholar] [CrossRef]
- Jayasinghe, C.; Fernando, T. First Report of Colletotrichum acutatum on Mangifera indica in Sri Lanka. Ceylon J. Sci. (Biol. Sci.) 2009, 38, 31034. [Google Scholar] [CrossRef]
- Sundelin, T.; Schiller, M.; Lübeck, M.; Jensen, D.; Paaske, K.; Petersen, B.D. First Report of Anthracnose Fruit Rot Caused by Colletotrichum acutatum on Strawberry in Denmark. Plant Dis. 2005, 89, 432. [Google Scholar] [CrossRef]
- Peres, N.A.R.; Souza, N.L.; Zitko, S.E.; Timmer, L.W. Activity of Benomyl for Control of Postbloom Fruit Drop of Citrus Caused by Colletotrichum acutatum. Plant Dis. 2002, 86, 620–624. [Google Scholar] [CrossRef]
- Shi, A.; Kantartzi, S.K.; Mmbaga, M.T.; Chen, P.; Mrema, F.; Nnodu, E. PCR-based markers for detection of Colletotrichum acutatum and C. gloeosporioides in flowering dogwood (Cornus florida). Australas. Plant Pathol. 2008, 37, 65–68. [Google Scholar] [CrossRef]
- Forcelini, B.B.; Peres, N.A. Widespread Resistance to QoI Fungicides of Colletotrichum acutatum from Strawberry Nurseries and Production Fields. Plant Health Prog. 2018, 19, 338–341. [Google Scholar] [CrossRef]
- Moreira, R.R.; Hamada, N.A.; Peres, N.A.; De Mio, L.L.M. Sensitivity of the Colletotrichum acutatum Species Complex from Apple Trees in Brazil to Dithiocarbamates, Methyl Benzimidazole Carbamates, and Quinone Outside Inhibitor Fungicides. Plant Dis. 2019, 103, 2569–2576. [Google Scholar] [CrossRef]
- Wedge, D.E.; Tabanca, N.; Sampson, B.J.; Werle, C.; Demirci, B.; Baser, K.H.C.; Nan, P.; Duan, J.; Liu, Z. Antifungal and Insecticidal Activity of two Juniperus Essential Oils. Nat. Prod. Commun. 2009, 4, 123–127. [Google Scholar] [CrossRef]
- Morkeliūnė, A.; Rasiukevičiūtė, N.; Šernaitė, L.; Valiuškaitė, A. The Use of Essential Oils from Thyme, Sage and Peppermint against Colletotrichum acutatum. Plants 2021, 10, 114. [Google Scholar] [CrossRef]
- PPDB: Pesticide Properties DataBase. Available online: http://sitem.herts.ac.uk/aeru/ppdb/en/Reports/536.htm (accessed on 24 May 2021).
- Quyen, N.T.T.; Thao, T.T.T.; Quyen, C.T.N.; Thuy, D.T.K.; Dong, L.M. Effect of calcium-alginate and essential oil on Colletotrichum acutatum and the shelf life of the grape. Vietnam. J. Sci. Technol. 2019, 57, 657. [Google Scholar] [CrossRef]
- Hong, J.K.; Yang, H.J.; Jung, H.; Yoon, D.J.; Sang, M.K.; Jeun, Y.C. Application of Volatile Antifungal Plant Essential Oils for Controlling Pepper Fruit Anthracnose by Colletotrichum gloeosporioides. Plant Pathol. J. 2015, 31, 269–277. [Google Scholar] [CrossRef]
- Singh, G.; Maurya, S.; Delampasona, M.; Catalan, C.A. A comparison of chemical, antioxidant and antimicrobial studies of cinnamon leaf and bark volatile oils, oleoresins and their constituents. Food Chem. Toxicol. 2007, 45, 1650–1661. [Google Scholar] [CrossRef]
- Smid, E.; Hendriks, L.; Boerrigter, H.; Gorris, L. Surface disinfection of tomatoes using the natural plant compound trans-cinnamaldehyde. Postharvest Biol. Technol. 1996, 9, 343–350. [Google Scholar] [CrossRef]
- Scariot, F.J.; Foresti, L.; Delamare, A.P.L.; Echeverrigaray, A.S. Activity of monoterpenoids on the in vitro growth of two Colletotrichum species and the mode of action on C. acutatum. Pestic. Biochem. Physiol. 2020, 170, 104698. [Google Scholar] [CrossRef]
- Duduk, N.; Markovic, D.; Vasić, M.; Duduk, B.; Vico, I.; Obradovic, A. Antifungal Activity of Three Essential Oils against Colletotrichum acutatum, the Causal Agent of Strawberry Anthracnose. J. Essent. Oil Bear. Plants 2015, 18, 529–537. [Google Scholar] [CrossRef]
- He, J.; Wu, D.; Zhang, Q.; Chen, H.; Li, H.; Han, Q.; Lai, X.; Wang, H.; Wu, Y.; Yuan, J.; et al. Efficacy and Mechanism of Cinnamon Essential Oil on Inhibition of Colletotrichum acutatum Isolated From ‘Hongyang’ Kiwifruit. Front. Microbiol. 2018, 9, 1288. [Google Scholar] [CrossRef] [PubMed]
- Costa, L.C.B.; Pinto, J.E.B.P.; Bertolucci, S.K.V.; Costa, J.C.D.B.; Alves, P.B.; Niculau, E.D.S. In vitro antifungal activity of Ocimum selloi essential oil and methylchavicol against phytopathogenic fungi. Rev. Ciênc. Agron. 2015, 46, 428–435. [Google Scholar] [CrossRef]
- Garcia, R.; Alves, E.S.; Santos, M.P.; Aquije, G.M.; Fernandes, A.A.R.; Santos, R.B.D.; Ventura, J.A.; Fernandes, P. Antimicrobial activity and potential use of monoterpenes as tropical fruits preservatives. Braz. J. Microbiol. 2008, 39, 163–168. [Google Scholar] [CrossRef]
- Quintana-Rodriguez, E.; Rivera-Macias, L.; Adame-Alvarez, R.M.; Torres, J.M.; Heil, M. Shared weapons in fungus-fungus and fungus-plant interactions? Volatile organic compounds of plant or fungal origin exert direct antifungal activity in vitro. Fungal Ecol. 2018, 33, 115–121. [Google Scholar] [CrossRef]
- Anthony, S.; Abeywickrama, K.; Wijeratnam, S.W. The effect of spraying essential oils of Cymbopogon nardus, Cymbopogon flexuosus and Ocimum basilicum on postharvest diseases and storage life of ‘Embul’ banana. J. Hortic. Sci. Biotechnol. 2003, 78, 780–785. [Google Scholar] [CrossRef]

| Lemongrass Oil | Cinnamon Bark Oil | Basil Oil | |||||||
|---|---|---|---|---|---|---|---|---|---|
| No. | KI | Compound | % | KI | Compound | % | KI | Compound | % |
| 1 | 975 | 6-Methylhelpt-5-en-2-one | 0.84 | 1023 | 1,8-Cineole | 4.54 | 1029 | 1,8-Cineole | 1.10 |
| 2 | 984 | β-Myrcene | 0.32 | 1113 | Linalool | 0.24 | 1102 | Linalool | 24.80 |
| 3 | 1027 | trans-β-Ocimene | 0.63 | 1158 | Borneol | 0.71 | 1205 | Methyl chavicol | 61.31 |
| 4 | 1103 | Linalool | 1.60 | 1219 | (Z)-Cinnamaldehyde | 10.90 | 1241 | Neral | 0.67 |
| 5 | 1147 | Lavandulol | 0.29 | 1275 | (E)-Cinnamaldehyde | 43.27 | 1272 | Geranial | 0.84 |
| 6 | 1155 | Citronellal | 0.65 | 1278 | Safrole | 26.69 | 1407 | α-Cedrene | 3.40 |
| 7 | 1167 | trans-Chrysanthenol | 0.50 | 1404 | α-Cedrene | 0.16 | 1430 | β-Copaene | 1.16 |
| 8 | 1186 | Isogeraniol | 1.79 | 1416 | β-Copaene | 0.45 | 1470 | γ-Gurjunene | 0.66 |
| 9 | 1205 | trans-Carveol | 0.31 | 1454 | trans-α-Bisabolene | 0.43 | 1505 | β-Bisabolene | 1.11 |
| 10 | 1218 | cis-Carveol | 1.98 | 1459 | δ-Cadinene | 0.24 | - | - | - |
| 11 | 1249 | Neral | 34.51 | 1663 | Tetradecanol | 0.72 | - | - | - |
| 12 | 1261 | Geraniol | 3.37 | 1698 | epi-α-Bisabolol | 0.41 | - | - | - |
| 13 | 1283 | Geranial | 34.62 | 1831 | 2-Phenylethyl benzoate | 0.34 | - | - | - |
| 14 | 1387 | Geranyl acetate | 2.63 | - | - | - | - | - | - |
| 15 | 1408 | E-Caryophyllene | 1.66 | - | - | - | - | - | - |
| 16 | 1571 | Caryophyllene oxide | 1.56 | - | - | - | - | - | - |
| Total % identified | 87.26 | 89.10 | 95.05 | ||||||
| Coriander Fruit Oil | Peppermint Oil | Orange Fruit Peel Oil | |||||||
|---|---|---|---|---|---|---|---|---|---|
| No. | KI | Compound | % | KI | Compound | % | KI | Compound | % |
| 1 | 981 | β-Pinene | 0.63 | 930 | α-Pinene | 0.69 | 910 | α-Thujene | 0.06 |
| 2 | 1000 | n-Octanal | 0.14 | 1030 | Limonene | 6.22 | 983 | β-Myrcene | 0.87 |
| 3 | 1025 | p-Cymene | 2.56 | 1145 | Menthone | 1.72 | 1033 | Limonene | 87.23 |
| 4 | 1028 | α-Myrcene | 2.82 | 1161 | Menthofuran | 1.78 | 1104 | n-Nonanal | 0.17 |
| 5 | 1058 | γ-Terpinene | 3.09 | 1169 | Menthol | 2.48 | 1145 | Limonene oxide | 0.07 |
| 6 | 1073 | cis-Linalool oxide | 0.11 | 1233 | Pulegone | 12.29 | 1189 | α-Terpineol | 0.09 |
| 7 | 1087 | Terpinolene | 0.18 | 1240 | Carvone | 61.55 | 1207 | Decanal | 0.19 |
| 8 | 1113 | Linalool | 55.33 | 1250 | Piperitone | 3.54 | 1388 | Geranyl acetate | 0.03 |
| 9 | 1141 | Camphor | 0.72 | 1435 | γ-Elemene | 0.21 | - | - | - |
| 10 | 1154 | Borneol | 0.20 | 1510 | Germacrene A | 0.11 | - | - | - |
| 11 | 1176 | Terpinene-4-ol | 0.50 | 1583 | Caryophyllene oxide | 0.62 | - | - | - |
| 12 | 1190 | α-Terpineol | 0.05 | 1644 | α-Muurolol | 0.74 | - | - | - |
| 13 | 1231 | Nerol | 0.18 | - | - | - | - | - | - |
| 14 | 1234 | Citronellol | 0.15 | - | - | - | - | - | - |
| 15 | 1260 | Geraniol | 1.37 | - | - | - | - | - | - |
| 16 | 1349 | Myrtenyl acetate | 0.54 | ||||||
| 17 | 1358 | Citronellyl acetate | 1.73 | ||||||
| 18 | 1369 | Neryl acetate | 4.25 | ||||||
| 19 | 1409 | β-Caryophyllene | 0.11 | ||||||
| 20 | 1468 | 2-Dodecenal | 0.23 | ||||||
| 21 | 1519 | γ-Cadinene | 0.05 | ||||||
| Total % identified | 74.94 | 91.95 | 88.71 | ||||||
| Fungal Strain | Diameter of Disease Lesions (mm) Recorded over Time | |||
|---|---|---|---|---|
| 6 D.A.I. | 9 D.A.I. | 12 D.A.I. | 15 D.A.I. | |
| Col 1 | 5.10 b | 11.7 ab | 16.5 a | 19.2 ab |
| Col 2 | 1.80 bc | 8.65 b | 11.9 b | 13.8 b |
| Col 5 | 9.90 a | 13.1 a | 15.5 ab | 20.0 a |
| Col 6 | 4.70 b | 9.55 ab | 11.6 b | 16.2 ab |
| Sterile DW | 0.00 c | 0.00 c | 0.00 c | 1.70 c |
| Treatment | Mean Fungal Growth Inhibition (mm) | |||
|---|---|---|---|---|
| 1 D.A.I. | 2 D.A.I. | 3 D.A.I. | 4 D.A.I. | |
| Lemongrass | 3.1 d | 1.8 c | 1.4 c | 1.1 c |
| Cinnamon bark | 14.2 b | 5.2 b | 4.0 b | 2.8 b |
| Basil | 6.0 c | 4.7 b | 3.6 b | 3.2 b |
| Orange peel | 0.0 f | 0.00 d | 0.00 e | 0.00 d |
| Peppermint | 1.4 e | 0.2 d | 0.8 cd | 0.00 d |
| Coriander seed | 0.9 ef | 0.3 d | 0.00 e | 0.00 d |
| Prochloraz | 17.0 a | 15.8 a | 15.8 a | 15.8 a |
| DMSO | 0.00 f | 0.00 d | 0.00 e | 0.00 d |
| EOs | MIC (µL/mL) |
|---|---|
| Cinnamon bark | 1.6 |
| Basil | 4 |
| Lemongrass | 12 |
| Orange peel | >32 |
| Peppermint | >32 |
| Coriander | >32 |
| Treatment | Lesion Diameter (mm) over Time | ||||
|---|---|---|---|---|---|
| 3 D.A.I. | 4 D.A.I. | 5 D.A.I. | 6 D.A.I. | 7 D.A.I. | |
| Basil oil | 2.25 bc | 4.40 bc | 5.62 b | 8.72 b | 10.41 b |
| Prochloraz | 2.00 c | 3.06 c | 4.06 b | 6.72 b | 8.59 b |
| 5% DMSO | 3.15 b | 6.53 ab | 10.19 a | 15.0 a | 16.91 a |
| Distilled water | 6.00 a | 9.59 a | 12.44 a | 16.53 a | 18.22 a |
Publisher’s Note: MDPI stays neutral with regard to jurisdictional claims in published maps and institutional affiliations. |
© 2021 by the authors. Licensee MDPI, Basel, Switzerland. This article is an open access article distributed under the terms and conditions of the Creative Commons Attribution (CC BY) license (https://creativecommons.org/licenses/by/4.0/).
Share and Cite
Danh, L.T.; Giao, B.T.; Duong, C.T.; Nga, N.T.T.; Tien, D.T.K.; Tuan, N.T.; Huong, B.T.C.; Nhan, T.C.; Trang, D.T.X. Use of Essential Oils for the Control of Anthracnose Disease Caused by Colletotrichum acutatum on Post-Harvest Mangoes of Cat Hoa Loc Variety. Membranes 2021, 11, 719. https://doi.org/10.3390/membranes11090719
Danh LT, Giao BT, Duong CT, Nga NTT, Tien DTK, Tuan NT, Huong BTC, Nhan TC, Trang DTX. Use of Essential Oils for the Control of Anthracnose Disease Caused by Colletotrichum acutatum on Post-Harvest Mangoes of Cat Hoa Loc Variety. Membranes. 2021; 11(9):719. https://doi.org/10.3390/membranes11090719
Chicago/Turabian StyleDanh, Luu Thai, Bui Thi Giao, Chau Trung Duong, Nguyen Thi Thu Nga, Doan Thi Kieu Tien, Nguyen Trong Tuan, Bui Thi Cam Huong, Tran Chi Nhan, and Dai Thi Xuan Trang. 2021. "Use of Essential Oils for the Control of Anthracnose Disease Caused by Colletotrichum acutatum on Post-Harvest Mangoes of Cat Hoa Loc Variety" Membranes 11, no. 9: 719. https://doi.org/10.3390/membranes11090719
APA StyleDanh, L. T., Giao, B. T., Duong, C. T., Nga, N. T. T., Tien, D. T. K., Tuan, N. T., Huong, B. T. C., Nhan, T. C., & Trang, D. T. X. (2021). Use of Essential Oils for the Control of Anthracnose Disease Caused by Colletotrichum acutatum on Post-Harvest Mangoes of Cat Hoa Loc Variety. Membranes, 11(9), 719. https://doi.org/10.3390/membranes11090719
